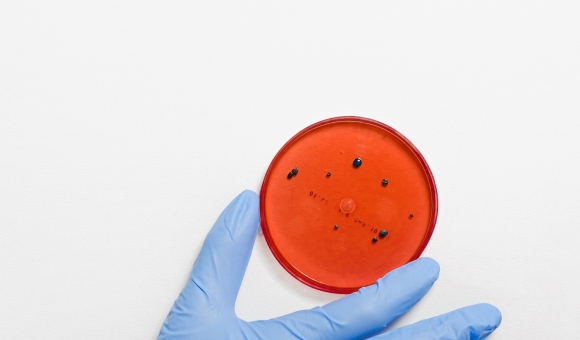

Nieuws


Voyaach komt op voor mensen zonder wettig verblijf in corona-tijden
31/03/2020De coronacrisis treft niet iedereen even hard. Mensen zonder wettig verblijf – een groep die in gewone omstandigheden reeds moeilijk in zijn basisbehoeften kan voorzien – hebben het nu extra moeilijk. De weinige (precaire) inkomensactiviteiten beschikbaar voor mensen zonder wettig verblijf liggen stil. De voedselhulp die doorgaans (maar beperkt) beschikbaar werd gesteld door organisaties en andere diensten is nu ook weggevallen. Dit is slechts een summiere opsomming van de obstakels die de corona-epidemie en de bijhorende maatregelen opwerpen.
Lees meer

Armoede-, vluchtelingen- en mensenrechtenorganisaties bundelen krachten en vragen interfederale taskforce voor mensen in kwetsbare positie
27/03/2020Nu zaterdag komen de partijvoorzitters bijeen om de huidige aanpak van de corona-crisis met de Federale regering te bespreken. Armoede-, vluchtelingen- en mensenrechtenorganisaties en vrijwilligersgroepen dringen erop aan dat alle partijen dit overleg op het hoogste niveau aangrijpen om een interfederale taskforce voor de ‘mensen in een kwetsbare positie’ op te richten. De organisaties, die over de nodige expertise, terreinkennis en netwerk beschikken, vragen hen hierbij te betrekken.
Lees meer
Armoedeorganisaties doen concrete aanbevelingen om hulp te bieden tijdens coronacrisis
17/03/2020Mensen in armoede hebben al moeilijker toegang tot zorg en dienstverlening. Tijdens een acute crisis zoals nu dreigen ze totaal in sociaal isolement te verzeilen en essentiële hulp mis te lopen. De armoedeorganisaties (Netwerk tegen Armoede, Samenlevingsopbouw, Welzijnsschakels, Welzijnszorg en ATD Vierde Wereld) doen concrete aanbevelingen aan lokale besturen, dienstverleners en scholen om mensen in armoede niet aan hun lot over te laten.
Lees meer

Alle externe bijeenkomsten opgeschort tot en met 13 april
13/03/2020Wij nemen onze verantwoordelijkheid en schorten alle externe bijeenkomsten op tot en met 13 april vanwege het coronavirus. Hoe jammer ook, maar we moeten kwetsbare mensen binnen en buiten onze doelgroep maximaal beschermen. Maar uitstel is geen afstel! Wie ingeschreven is voor een van onze activiteiten, wordt persoonlijk gecontacteerd. Wij houden jullie op de hoogte van nieuwe data. Wij blijven bereikbaar via de contactgegevens op onze website.
Lees meer

Mensen in armoede zijn de enige echte deskundigen
06/03/2020Armoedebestrijding kan pas succes boeken als ze gebeurt samen met mensen in armoede en niet enkel voor of over hen. Toch zien we dat onze samenleving worstelt met participatie van mensen in armoede. De vooroordelen zijn hardnekkig. Onze landelijke vereniging ATD Vierde Wereld stelt vast dat de strijd voor participatie nog niet gestreden is.
Lees meer

Netwerk tegen Armoede voert mee actie tegen besparingen in social profit
05/03/2020De besparingen op diverse sectoren en organisaties in de social profit hebben wel degelijk impact voor mensen die zorg of hulp nodig hebben. Net de meest kwetsbaren dreigen op die manier uit de boot te vallen. Zorg en welzijn verdienen investeringen als we van Vlaanderen een warme, solidaire regio willen maken. Daarom stapte het Netwerk tegen Armoede mee op in de betoging tegen het kille, Vlaamse besparingsbeleid.
Lees meer

Picknick Solidair voor 50 jaar Welzijnszorg op 30 mei in Leuven
05/03/2020Kom mee picknicken om te tonen dat je solidair bent met mensen in armoede en kwetsbare groepen! En om te vieren dat we al 50 jaar samen met Welzijnszorg strijden tegen armoede. Jij brengt je picknick mee. Welzijnszorg zorgt voor muziek, informatie, (gezins)animatie, bezoeken, workshops, een podiumprogramma en de uitreiking van de Prijs Armoede Uitsluiten.
We plakken de solidariteitsmuur vol met jouw affiches! Bereid er eentje voor, samen met je vrijwilligers en/of collega’s. Want jij kunt je steentje bijdragen! Lees op Welzijnszorg.be/Solidariteitsmuur hoe jullie aan de slag kunnen gaan om samen affiches tegen armoede te maken. Iedereen is welkom op dit gratis evenement op zaterdag 30 mei op het Hooverplein in Leuven. Ontdek het programma en schrijf je als groep in via de website www.welzijnszorg.be. Dan liggen jullie goodiebags alvast klaar!
Lees meer

Politici, neem uw verantwoordelijkheid
26/02/2020Netwerk tegen Armoede pleit samen met 56 andere middenveldorganisaties voor daadkracht bij de federale regeringsvorming. Politici moeten uit hun loopgraven komen en werk maken van een nieuwe regering. De sociale uitdagingen zijn te groot om zich te verliezen in politieke stratego.
Lees meer

Het middenveld in Vlaanderen: en avant marche! - 4 februari in Gent
15/01/2020Na vier jaar intensief onderzoek, debat en overleg over de uitdagingen voor middenveldorganisaties en innovatieve antwoorden erop, gaat CSI Flanders op 4 februari 2020 in Gent met u in gesprek over de belangrijkste resultaten van het onderzoek. Deze slotconferentie geeft een inkijk in het volledige onderzoek, wil inspiratie geven vanuit onderzoek naar concrete cases van vernieuwing in het middenveld, voedt het debat over actuele uitdagingen voor middenveldorganisaties en formuleert een agenda voor de toekomst.
Een razend actuele bijeenkomst dus die u niet mag missen.


3-daagse vorming
10/01/2020Armoede roept heel wat vragen op in onze samenleving! Tijdens deze 3-daagse vorming gaat het Netwerk tegen Armoede dieper in op deze vragen en worden er - samen met mensen met ervaringskennis in armoede – mogelijke antwoorden geformuleerd.
Lees meer

Mensen in armoede: "Vlaamse regering kan werk maken van betere rechtentoekenning."
08/01/2020e Vlaamse regering heeft nog veel marge om rechten beter toe te kennen voor mensen in armoede. Dat laten ze zelf blijken in de jaarlijkse eindejaarsbevraging van het Netwerk tegen Armoede. De automatische toekenning van de schooltoeslag (participatietoeslag) door de vorige Vlaamse regering is alvast een stap vooruit. Maar ook in toekenning van sociale tarieven (energie, water) of sociale abonnementen (openbaar vervoer) kunnen nog belangrijke stappen vooruit gezet worden.
Lees meer

Steun Netwerk tegen Armoede tijdens de Warmste Week
13/12/2019De Warmste Week staat voor de deur en daarbij kunt u opnieuw de strijd tegen armoede een stevige duw in de rug geven. Zet een actie op of vraag een plaat aan ten voordele van Netwerk tegen Armoede. Zo helpt u mensen in armoede uit hun isolement breken, sterker worden en zelf oplossingen bedenkingen die de armoede en sociale uitsluiting terugdringen.
Lees meer

Inspiratiegids: Diva's in diversiteit - samen tegen armoede
10/12/2019Als vrouwen van verschillende achtergronden elkaar ontmoeten, ontkiemt er iets moois! Drie jaar lang al ontmoeten vrouwen met een migratieachtergrond en KVLV-leden elkaar binnen het project DIVA’s Samen tegen Armoede. Samen zetten ze in op de strijd tegen armoede en sociale uitsluiting. Een project van KVLV, samen met Netwerk tegen Armoede, Minderhedenforum en Cera.
Lees meer

Zet je in als vrijwilliger tijdens De Warmste Week
22/11/2019De dagen worden korter en kouder. Dat betekent dat De Warmste Week in aantocht is. In heel Vlaanderen worden her en der acties gevoerd om de Goede Doelen te ondersteunen door extra geld in het laatje te brengen.
Dit jaar gaat De Warmste Week echter verder, en roepen we iedereen op om wat tijd te geven; voor en tijdens De Warmste Week en zo kennis te maken met het vrijwilligerswerk.
Lees meer

Vuurwerk: warme samenleving heeft sterk middenveld nodig
21/11/2019Het Netwerk tegen Armoede steunt het protest tegen de besparingen in het sociale middenveld en cultuur. Dit zet veel kwetsbare mensen én honderdduizenden vrijwilligers in de kou, terwijl vzw's en cultuurorganisaties ook een hefboom zijn voor tewerkstelling en maatschappelijk engagement.
Lees meer
Een origineel eindejaarscadeau? Steun Netwerk tegen Armoede via Good Gifts!
06/11/2019Good Gifts pakt dit eindejaar uit met een originele geschenkformule, waarbij u aan uw dierbaren een origineel cadeau schenkt én een goed doel steunt. Netwerk tegen Armoede is een van de goede doelen die uw steun kunnen krijgen. Hoe werkt het? Via de ...
Lees meer
Boek: Aan de onderkant ligt de lat altijd hoger
15/10/2019Guy Malfait en Marijke Decuypere van ATD Vierde Wereld schreven een boek over het leven aan de onderkant van de armoedegrens. Waar mensen voortudrend op drempels en obstakels botsen en tegen muren aanlopen. Maar ook veel veerkracht en creativiteit ...
Lees meer
Armoedebestrijding wordt vooral een strijd tegen mensen in armoede
01/10/2019Het Netwerk tegen Armoede kan niet anders dan teleurgesteld zijn over het regeerakkoord dat N-VA, Open VLD en CD&V na lange onderhandelingen afklopten. Armoedebestrijding lijkt verworden tot een strijd tegen mensen in armoede. Met deze plannen lijkt ...
Lees meer
DIVA's: de kracht van lokale ontmoeting tussen culturen
25/09/2019Hoe kunnen lokale ontmoetingen tussen vrouwen uit verschillende culturen mensen sterker maken en armoedebestrijding op de agenda zetten? Dat onderzochten Cera, Minderhedenforum, KVLV-Vrouwen met Vaart en Netwerk tegen Armoede in verschillende ...
Lees meer
Zonder middenveld zijn mensen op zichzelf aangewezen
04/09/2019Een brede coalitie van 78 middenveldorganisaties, waaronder Netwerk tegen Armoede, doen een warme oproep om te blijven investeren in dat Vlaamse middenveld. Zonder organisaties die mensen ondersteunen en voor hun belangen opkomen, zijn mensen op ...
Lees meer
Ons Centrum krijgt veel bijval voor theatervoorstelling Groei
25/06/2019Ons Centrum, een bruisende Vereniging Waar Armen het Woord Nemen uit Leopoldsburg, speelde op 28 april hun nieuwe theatervoorstelling ‚'Groei‚' in het CC Leopoldsburg. Deze voorstelling was het derde sociaal artistiek project waarin mensen uit de ver ...
Lees meer
Recht-Op Jongeren brengt fotoreeks over hoop en wanhoop
11/06/2019De jongeren van Recht-Op werkten hard! Samen met een ervaren fotograaf gingen ze de voorbije maanden aan de slag met fotografie. Ze leerden de technische en artistieke aspecten van het medium kennen en onderzochten hoe fotografie taal kan bieden aan ...
Lees meer
Inzicht in armoede: het verhaal van Cindy
08/06/2019"Vandaag groeien in ons land nog steeds duizenden kinderen op in armoede. Dat is onaanvaardbaar. Iedereen heeft recht op een menswaardig bestaan, en ik ben vastbesloten om te blijven groeien in mijn job, zodat ik kan opkomen voor hen die het door ...
Lees meer
De Schakel uit Puurs wint Prijs Armoede Uitsluiten van jubilaris Welzijnszorg
07/06/2019Andermaal een mooie erkenning voor een van onze verenigingen waar armen het woord nemen. De Schakel uit Puurs werd bekroond met de Prijs Armoede Uitsluiten van Welzijnszorg, goed voor een bedrag van €20.000. De Schakel krijgt de prijs voor hun j ...
Lees meer

Wie nu geen werk maakt van armoedebestrijding, pleegt schuldig verzuim
07/06/2019De verkiezingsuitslag van 26 mei doet de alarmbellen afgaan. Dat zoveel mensen hun toevlucht zoeken tot extreemrechts heeft verschillende redenen. Dit is geen resultaat om vrolijk van te worden, wel een alarmsignaal om te kijken waarom mensen zich afkeren van de politiek, waarvan ze niet meer geloven dat die een oplossing kan bieden voor hun problemen.
Lees meer
#komafmetarmoede: schud politici wakker met een concreet voorstel
29/05/2019Deel & steun mee de #Komafmetarmoede campagne! Hoe doe je dat? Ga naar www.komafmetarmoede.be Kies een voorstel en daarna de kandidaat die je wilt wakker schudden. Zo dagen we onze verkozen politici uit om minstens één voorstel te adopteren. Maak zo m ...
Lees meer
De Zuidpoort en ATD Vierde wereld winnen Federale Prijs Armoedebestrijding
22/05/2019De Zuidpoort en ATD Vierde Wereld werden vandaag allebei bekroond met de Federale Prijs Armoedebestrijding. Een mooie erkenning waar beide verenigingen terecht trots op zijn. De financiële beloning die eraan verbonden is, zullen beide organisaties ...
Lees meer

Tien prioriteiten voor de verkiezingen 2019
12/05/2019De Vlaamse, federale en Europese verkiezingen komen steeds dichterbij. Op 26 mei trekken we alweer naar de stembus. Het Netwerk tegen Armoede wil graag tien prioriteiten verwezenlijkt zien in de volgende regeerperiode. de prioriteiten zullen de basisleidraad vormen bij de onderhandelingen voor het regeerakkoord. De tien prioriteiten bestrijken verschillende grondrechten. Zo pleit het Netwerk natuurlijk voor het optrekken van de laagste uitkeringen tot de Europese armoedegrens, maar ook voor een garantie op duurzaam en kwaliteitsvol werk, een veralgemeende derdebetalersregeling, een automatische toekenning van sociale tarieven voor abonnementen van openbaar vervoer, etc.
Lees meer Download
Studiedag 22 november (nieuwe datum!): Dialoog versterken in tijden van wantrouwen
10/05/2019Hoe versterk je de dialoog met en tussen kwetsbare mensen in een tijd waarin het wantrouwen onze samenleving tekent? De Beweging van Mensen met Laag Inkomen en Kinderen zoekt naar antwoorden op die vragen tijdens een studiedag naar aanleiding van de ...
Lees meer
De stressweg: vorming voor sterke hulpverleningsgesprekken
25/03/2019Mensen in armoede ervaren heel wat stress in (hulpverlenings)gesprekken. Terwijl die gesprekken helpend bedoeld zijn, hebben ze vaak het omgekeerde effect. De mensen van onze vereniging De Zuidpoort in Gent doken in het thema, maakten er ...
Lees meer
